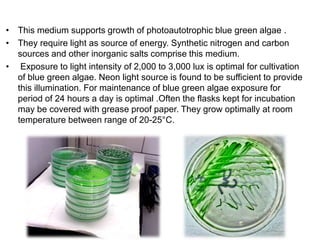
• This medium supports growth of photoautotrophic blue green algae .
• They require light as source of energy. Synthetic nitrogen and carbon
sources and other inorganic salts comprise this medium.
• Exposure to light intensity of 2,000 to 3,000 lux is optimal for cultivation
of blue green algae. Neon light source is found to be sufficient to provide
this illumination. For maintenance of blue green algae exposure for
period of 24 hours a day is optimal .Often the flasks kept for incubation
may be covered with grease proof paper. They grow optimally at room
temperature between range of 20-25°C.

This document discusses various microbiological techniques used to study microorganisms, including:
1. Microscopic, cultural, physiological, immunological, and molecular methods. Specific techniques mentioned are Gram staining, growth media selection, enzyme activity assays, immunoassays, DNA fingerprinting, gene probes, microarrays, PCR, and metagenomics.
2. 16S rRNA gene sequencing is described as the most widely used molecular technique for bacterial identification and phylogenetic analysis due to the conserved nature of the 16S rRNA gene.
3. Metagenomics provides information on the collective genomes of microorganisms in an environmental sample to study microbial diversity and ecology.